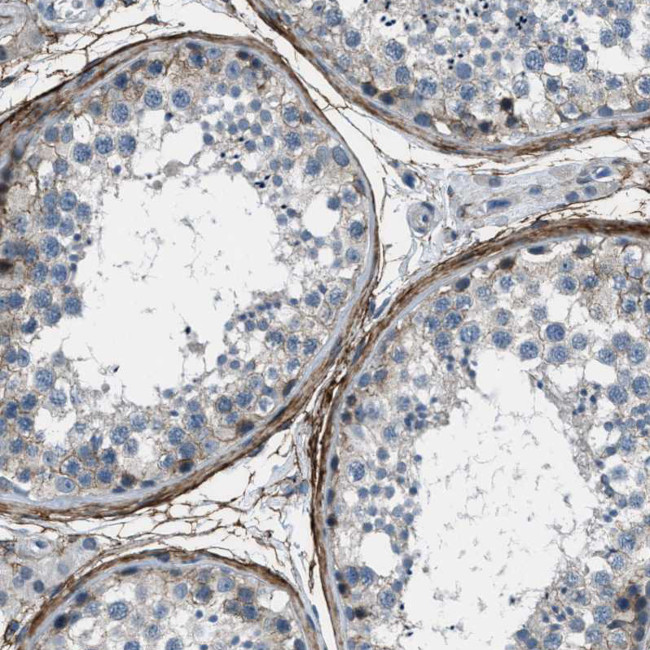
Fibrillin 1 Antibody in Immunohistochemistry (Paraffin) (IHC (P))

Search
Invitrogen
Fibrillin 1 Polyclonal Antibody
{{$productOrderCtrl.translations['antibody.pdp.commerceCard.promotion.promotions']}}
{{$productOrderCtrl.translations['antibody.pdp.commerceCard.promotion.viewpromo']}}
{{$productOrderCtrl.translations['antibody.pdp.commerceCard.promotion.promocode']}}: {{promo.promoCode}} {{promo.promoTitle}} {{promo.promoDescription}}. {{$productOrderCtrl.translations['antibody.pdp.commerceCard.promotion.learnmore']}}
产品信息
PA5-82598
种属反应
宿主/亚型
分类
类型
抗原
偶联物
形式
浓度
规格
纯化类型
保存液
内含物
保存条件
运输条件
RRID
产品详细信息
Immunogen sequence: HCVSGMGMGR GNPEPPVSGE MDDNSLSPEA CYECKINGYP KRGRKRRSTN ETDASNIEDQ SETEANVSLA SWDVEKTAIF AFNISHVSNK VRILELLPAL TTLTNHNRYL IESGNEDGFF KINQKEGISY LHFTKKKPVA GTYSLQISS
Highest antigen sequence indentity to the following orthologs: Mouse - 92%, Rat - 91%.
靶标信息
Fibrillin 1 is an extracellular acidic protein with a high cysteine content and an extended thread-like shape with mosaic composition of different types of extracellular modules. Most of the fibrillin molecule is contributed by 47 epidermal growth factor-like (EGF-like) repeats; 43 of them have a consensus sequence for calcium binding (cb). Other modules including 8-cysteine motifs (seven), hybrid motifs (two), and unique domains (three) are interspersed throughout the molecule[3-7]. Fibrillin 1 contains a proline-rich region close to the N-terminus that is replaced by a glycine-rich region in Fibrillin 2. The fibrillins are found throughout the connective tissue as integral components of extended fibrils.
仅用于科研。不用于诊断过程。未经明确授权不得转售。
篇参考文献 (0)
生物信息学
蛋白别名: asprosin; epididymis secretory sperm binding protein; fibrillin 15; Fibrillin-1; fibrillin-1 preproprotein; unnamed protein product
基因别名: ACMICD; ECTOL1; FBN; FBN1; GPHYSD2; MASS; MFLS; MFS1; OCTD; SGS; SSKS; WMS; WMS2
UniProt ID: (Human) P35555
Entrez Gene ID: (Human) 2200